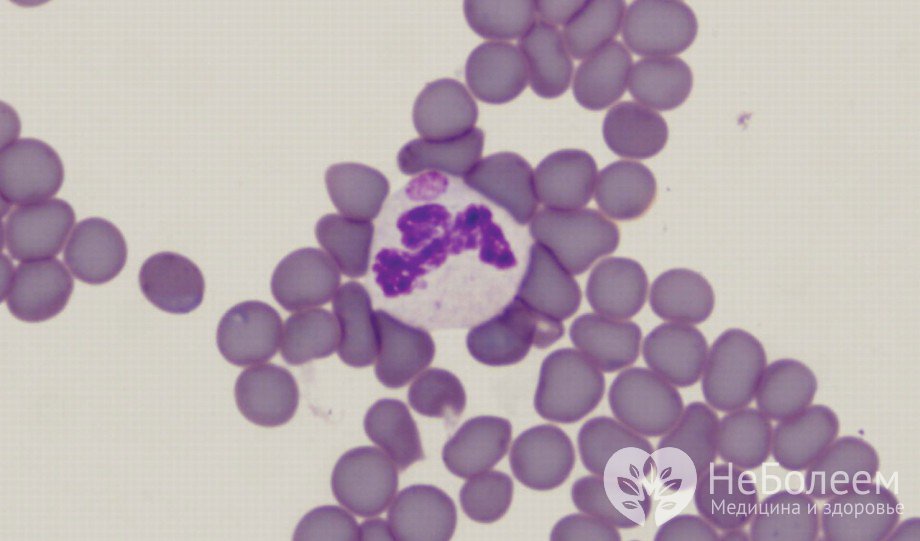
Симптомы анаплазмоза

Воспользуйтесь поиском по сайту:
Анаплазмоз
Содержание статьи:
Анаплазмоз – острое трансмиссивное инфекционное заболевание с полиморфной клиникой, возбудитель которого, анаплазма (Anaplasma phagocytophillum), переносится иксодовыми клещами.
До 1991 года, когда в США впервые был диагностирован анаплазмоз человека, считалось, что иксодовые клещи могут переносить возбудителей только клещевого энцефалита и боррелиоза (болезнь Лайма). На настоящий момент в структуре клещевых трансмиссивных заболеваний анаплазмоз занимает второе место по частоте встречаемости. На территории Российской Федерации инфицированность возбудителями анаплазмоза встречается у 6–19% иксодовых клещей.
Для заболевания характерна сезонность, совпадающая с периодом наибольшей активности и повышенной численности переносчиков и приходящаяся на весну-лето. Больной человек не представляет инфекционной опасности для окружения.
Синоним: гранулоцитарный анаплазмоз человека (ГАЧ).
Возбудитель анаплазмоза – мелкая бактерия анаплазма
Возбудитель анаплазмоза – мелкая бактерия анаплазмаПричины и факторы риска
Возбудитель заболевания – мелкая бактерия анаплазма. Это внутриклеточный паразит, размножающийся в клетках крови человека.
При укусе клеща вместе с его слюной анаплазма попадает в системный кровоток, где колонизирует зрелые нейтрофилы (гранулоциты). Бактерия, доставленная в ткани внутренних органов с током крови, провоцирует в них воспалительные изменения. Дальнейшее размножение анаплазмы в клетках крови влечет угнетение иммунитета и, как следствие, присоединение вторичных бактериальных, вирусных и грибковых инфекций.
Инкубационный (скрытый) период анаплазмоза колеблется от 3 дней до 3 недель (в среднем до 14 дней) с момента попадания возбудителя в организм человека.
Помимо клещей, резервуаром инфекции в природе являются сельскохозяйственные и дикие животные: грызуны, парнокопытные, представители семейства собачьих, а также птицы, миграция которых способствует широкому распространению инфицированных клещей. Анаплазмия у животных сохраняется в течение нескольких недель; в данный период они становятся источником инфекции для ранее интактных (незараженных) клещей.
Основные факторы риска развития анаплазмоза:
- контакт с сельскохозяйственными и дикими животными, особенно в весенне-летний период;
- пренебрежение средствами защиты при нахождении в местах наиболее вероятного скопления клещей (на лесных и лесопарковых территориях).
 Иксодовые клещи – основные переносчики бактерии анаплазмы, возбудителя анаплазмоза
Иксодовые клещи – основные переносчики бактерии анаплазмы, возбудителя анаплазмозаФормы заболевания
В соответствии со степенью выраженности клинической картины заболевания выделяют следующие его формы:
- бессимптомная (субклиническая);
- манифестная.
В зависимости от тяжести протекания анаплазмоз бывает легким, средней степени и тяжелым.
Симптомы
Заболевание проявляется широким спектром разнообразных симптомов, выраженность которых варьирует в зависимости от тяжести протекания. Инкубационный (скрытый) период колеблется от 3 дней до 3 недель (в среднем до 14 дней) с момента попадания возбудителя в организм человека.
При легкой форме заболевания симптомы напоминают клинику острой респираторной вирусной инфекции:
- острое начало;
- резкое повышение температуры тела (более 38,0–38,5 °С);
- потрясающие ознобы;
- общая слабость;
- тошнота, снижение или полное отсутствие аппетита;
- головная боль;
- мышечные и суставные боли;
- в некоторых случаях боль и першение в горле, кашель, рвота, диарея, чувство тяжести в правом подреберье.
При среднетяжелом течении симптомы более разнообразны и интенсивны, к описанным ранее проявлениям присоединяются следующие:
- неврологические нарушения (головная боль, головокружение);
- неукротимая рвота;
- одышка;
- уменьшение мочеотделения вплоть до анурии;
- отеки;
- брадикардия, понижение артериального давления;
- тяжесть и чувство распирания в правом подреберье.
При тяжелом течении заболевания, более характерном для лиц с иммунодефицитом, отмечаются:
- высокая упорная лихорадка длительностью до 2-3 недель;
- интенсивная неврологическая симптоматика, нередко с общемозговыми симптомами (нарушениями сознания различной степени выраженности (от состояния оглушения до комы), генерализованными судорожными приступами);
- кровотечения (появление следов крови в испражнениях и рвотных массах, окрашивание мочи в розовый цвет);
- перебои в работе сердца, аритмия.
Читайте также:10 мифов о клещах и энцефалите
Диагностика
Диагностика на основании клинической картины значительно затруднена ввиду неспецифичности проявлений.
Возбудитель анаплазмоза – мелкая бактерия анаплазма. Это внутриклеточный паразит, размножающийся в клетках крови человека.
Для корректной постановки диагноза необходим тщательный сбор анамнестических данных, подтверждающий факт укуса клеща, проживание или пребывание в районе, эндемичном по трансмиссивным инфекциям, посещение леса, лесопарковой зоны в предшествующий период до 3 недель.
Проводятся следующие лабораторные исследования:
- общий анализ крови (выявляются лейкопения с нейтрофильным сдвигом лейкоцитарной формулы влево, умеренное увеличение СОЭ, возможно – анемия и тотальное снижение количества всех клеток крови);
- общий анализ мочи (устанавливаются гипоизостенурия, протеинурия, гематурия различной выраженности);
- биохимический анализ крови (на повышение активности печеночных ферментов (АСТ, АЛТ, ЛДГ), креатинина и мочевины, увеличение концентрации С-реактивного белка);
- прямая темнопольная микроскопия тонкого мазка, окрашенного по Романовскому – Гимзе (наиболее информативна в острый период, при высокой концентрации возбудителя, позволяет выявить колонии анаплазмы в клетках крови);
- полимеразная цепная реакция (ПЦР) для выявления ДНК возбудителя (в данном случае используются плазма крови, спинномозговая жидкость пострадавшего или сам клещ в случае его своевременного обнаружения);
- иммуноферментный анализ (ИФА);
- непрямая реакция иммунофлюоресценции (НРИФ).
 Исследование клеща помогает выявить ДНК возбудителя
Исследование клеща помогает выявить ДНК возбудителяОсуществляются инструментальные исследования:
- рентгенография легких (устанавливаются признаки бронхита или пневмонии, увеличение регионарных лимфатических узлов);
- ЭКГ (определяются признаки нарушения проводимости);
- УЗИ органов брюшной полости (на увеличение печени, диффузные изменения тканей органа).
Лечение
Приблизительно половина пациентов с диагнозом «анаплазмоз» нуждается в госпитализации и стационарном лечении.
Основной метод лечения – этиотропная антибиотикотерапия препаратами тетрациклинового ряда. Если антибактериальные препараты назначены в течение 3 дней после присасывания клеща, используется сокращенная схема антибиотикопрофилактики (5–7 дней).
Для детей, беременных и кормящих женщин препаратами выбора являются Амоксициллин или защищенные пенициллины в возрастных дозировках.
 Прием антибиотиков – основной метод лечения анаплазмоза
Прием антибиотиков – основной метод лечения анаплазмозаПри необходимости в качестве дополнительных средств используются:
- противовоспалительные препараты;
- гепатопротекторы;
- витаминные препараты;
- антипиретики;
- анальгетики;
- препараты для лечения сопутствующих нарушений (неврологических, кардиологических, респираторных и т. д.).
Возможные осложнения и последствия
Осложнения при ГАЧ как моноинфекции наблюдаются редко; тяжесть течения усиливается при клещевых вирусно-бактериальных смешанных инфекциях, которые приводят:
- к кровотечениям;
- к острой почечной недостаточности;
- к острой печеночной недостаточности;
- к дыхательной недостаточности;
- к гепатиту;
- к менингоэнцефалиту;
- к инфекционно-токсическому шоку;
- к коагулопатии;
- к миокардиту;
- к атипичной пневмонии;
- к коме, летальному исходу.
Прогноз
При своевременно начатой терапии прогноз благоприятный. Однако у пациентов с тяжелой сопутствующей патологией, иммунодефицитными состояниями заболевание может повлечь развитие тяжелых, иногда жизнеугрожающих осложнений, летальный исход.
На территории Российской Федерации инфицированность возбудителями анаплазмоза встречается у 6–19% иксодовых клещей.
Профилактика
- Снижение численности клещей в природных очагах с помощью дезинсекционных мероприятий.
- Использование акарицидов и защитной одежды, максимально закрывающей поверхность тела, при нахождении в местах предположительного обитания клещей.
- Соблюдение гигиенических норм при взаимодействии с сельскохозяйственными животными.
- Избегание контакта с дикими животными.
- В случае обнаружения присосавшегося клеща – его раннее удаление с последующим обязательным исследованием.
Видео с YouTube по теме статьи:
Об авторе

Информация является обобщенной и предоставляется в ознакомительных целях. При первых признаках болезни обратитесь к врачу. Самолечение опасно для здоровья!
Согласно исследованиям ВОЗ ежедневный получасовой разговор по мобильному телефону увеличивает вероятность развития опухоли мозга на 40%.
























